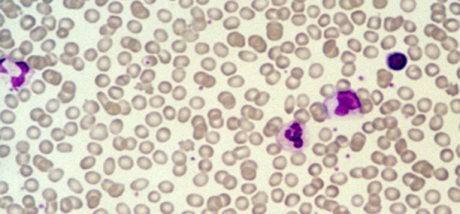

ΜΙΚΡΟΣΚΟΠΙΚΗ ΑΠΕΙΚΟΝΙΣΤΙΚΗ
ΚΥΤΤΑΡΟΛΟΓΙΚΟ ΤΜΗΜΑ
Παρεχει τη δυνατοτητα υποστηριξης αλλα και τεκμηριωσης διαγνωσεων.Γινεται με ψηφιακα οργανα(μικροσκοπια)και παρεχει πληροφοριες στο πεδιο της κυτταρολογικης αναλυσης,(κυτταρα αιματος,ουρου,ιστων),στο πεδιο μικροβιων,μυκητων,ρικετσιων και πρωτοζωων,οπως και στο παρασιτολογικο πεδιο.
Μια δυνατοτητα διαχωρισμου και εναλλακτικης προσεγγισης σε κυτταρικο επιπεδο.
Η κυτταρικη μορφολογια,αριθμος και αναλυση ειναι τα στοιχεια που εδω δινουν πληροφορια και οι μεταβολες αυτες αναλυονται και συσχετιζονται,με κλινικα ευρηματα η ευρηματα αλλων εξετασεων.Αρκετες δε φορες λειτουργουν διαγνωστικα αυτονομα.
Αναλυονται υλικα και ιστοι που συλλεγονται και παρασκευαζονται με ειδικο τροπο αναλογα την περιπτωση και αποτελει ενα διαγνωστικο παραθυρο,πολλες φορες κρισιμο,για την επιβεβαιωση η διαφοροποιηση,ακομα και διφορουμενων η αμφιλεγομενων καταστασεων.
Απαιτει εξειδικευση στη συλλογη και παρασκευη των υλικων εξετασης,αλλα και στο πεδιο της εξετασης και κυτταρικης αναγνωσης.
Οι απεικονισεις αποτελουν τεχνολογικη δυνατοτητα του χωρου
Οι κυτταρικες ταυτοποιησεις τεχνογνωσια του κυτταρολογικου τμηματος
Στην υπηρεσια της μεγαλυτερης δυνατης προσεγγισης στην διαγνωστικη των ζωων και την καλυτερη δυνατη αποδοση θεραπειων και ευζωιας τους.

Hemangiopericytoma dog.Κυτταρολογικη διερευνυση – απεικονιση.(Δειγμα απο διογκωση μαλακων μοριων σε περιοχη αγκωνα σκυλου).

Κυτταρολογικες απεικονισεις – δειγμα ιστοι – ολικο αιμα.
[flgallery id=37 /]
Κυτταρολογικη απεικονιση – δειγμα ουρο.
Η εξεταση ιζηματος ουρου ειναι πολυ σημαντικη,προσφερει πληροφοριες,σε συνδιασμο με τη γενικη εξεταση ουρου,βοηθαει στην αναγνωριση της πηγης προελευσης,αρα στη διαγνωση,αποτελωντας μικροσκοπικη εξεταση ρουτινας.
[flgallery id=38 /]
ΠΑΡΣΙΤΟΛΟΓΙΚΟ ΤΜΗΜΑ.
 Προσφερεται η δυνατοτητα υποστηριξης οπου απαιτειται, απο το παρασιτολογικο τμημα,με δυνατοτητα ψηφιακης αναλυσης και απεικονισης.Η ληψη δειγματων,οι μεθοδοι και η αναγνωριση-αποτελεσματα,ειναι κτημα του χωρου.Το τμημα λειτουργει αυτονομα διαγνωστικα η υποστηρικτικα,οπου η περισταση το απαιτει,κατ αναγκη και εντολη των κλινικων κτηνιατρων.
Προσφερεται η δυνατοτητα υποστηριξης οπου απαιτειται, απο το παρασιτολογικο τμημα,με δυνατοτητα ψηφιακης αναλυσης και απεικονισης.Η ληψη δειγματων,οι μεθοδοι και η αναγνωριση-αποτελεσματα,ειναι κτημα του χωρου.Το τμημα λειτουργει αυτονομα διαγνωστικα η υποστηρικτικα,οπου η περισταση το απαιτει,κατ αναγκη και εντολη των κλινικων κτηνιατρων.
Υπαρχουν πεντε κατηγοριες παρασιτικων εντοπισεων και η ανιχνευση τους αφορα σε διαφορετικες διαδικασιες αναγνωρισης ταυτοποιησης και τροπους παρασκευης δειγματων. demodex
1.Δερματολογικα
2.Εντερικα
3.Παρασιτα αιματος
4.Αναπνευστικα
5.Οφθαλμικα
Τα δερματολογικα παρασιτικα νοσηματα,αποτελουν συχνη κλινικη κατασταση και επισης συχνα,συγχεονται με αλλες δερματολογικες παθησεις,με αποτελεσμα κακες,οχι αιτιολογικες θεραπευτικες πρακτικες και μακροχρονια ταλαιπωρια του ζωου.Για αυτο,τετοιου τυπου εξεταση αποτελει και πρεπει να ειναι συχνη διαδικασια ελεγχου επι υποψιας.
Απεικονιση δερματολογικων παρασιτων -ενηλικα-αυγα-
[flgallery id=39 /]
Ενα αλλο πεδιο παρασιτολογικου ελεγχου ειναι τα εντερικα παρασιτα.Οι εντερικες παρασιτικες ασθενειες μπορει να αποτελουν επιμονο προβλημα,αναλογα την ηλικια του ζωου(κυριως σε νεαρης ηλικιας ζωα),αλλα και την περιοχη διαβιωσης.
Για αυτο ειναι επισης σημαντικη περαν αλλων και διαφορων πιθανων εξετασεων,αυτη η διαδικασια ελεγχου και ταυτοποιησης.
Η εξεταση απαιτει:
α)δειγμα κοπρανων (κοπρανολογικη)
β)δειγμα βλενογοννου εντερου.
Αυτο το τελευταιο χρησιμοποιειται και για αλλου τυπου κυτταρολογικη αναγνωριση καθως και μικροβιακη ταυτοποιηση.
Giardia
[KGVID width=”640″ height=”360″]https://avc-vet.com/wp-content/uploads/2014/09/logothetis4.mp4[/KGVID]
Ψηφιακη Μικροσκοπικη Βιντεοσκοπιση scabies και demodex απο δερματολογικα δειγματα σκυλου.
[KGVID width=”640″ height=”360″]https://avc-vet.com/wp-content/uploads/2014/09/avc1.mp4[/KGVID]
VIODEODIAGNOSIS ΒΙΝΤΕΟΔΙΑΓΝΩΣΤΙΚΗ
Παρεχεται η δυνατοτητα διαγνωστικης μεσω συστηματων video οπου ειναι αδυνατη η αλλου τυπου προσβαση,η οπου απαιτειται εικονα μεγαλης ευκρινειας.Αυτι,Ματι,Στοματικη κοιλοτητα,Λαρυγγας,Φαρυγγας ειναι μερικα απο τα οργανα που απαιτουν τετοιου ειδους προσβασιμοτητα.